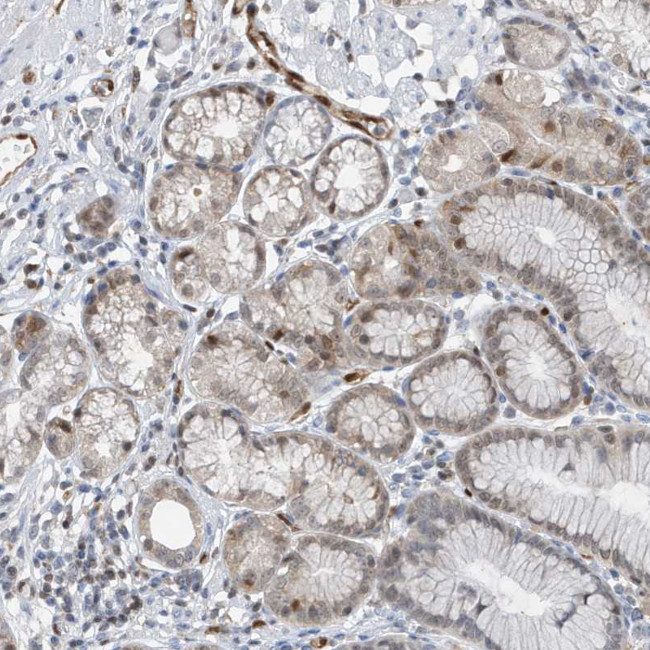
NCOA7 Antibody in Immunohistochemistry (Paraffin) (IHC (P))

Search
Invitrogen
NCOA7 Polyclonal Antibody
{{$productOrderCtrl.translations['antibody.pdp.commerceCard.promotion.promotions']}}
{{$productOrderCtrl.translations['antibody.pdp.commerceCard.promotion.viewpromo']}}
{{$productOrderCtrl.translations['antibody.pdp.commerceCard.promotion.promocode']}}: {{promo.promoCode}} {{promo.promoTitle}} {{promo.promoDescription}}. {{$productOrderCtrl.translations['antibody.pdp.commerceCard.promotion.learnmore']}}
产品信息
PA5-56430
种属反应
宿主/亚型
分类
类型
抗原
偶联物
形式
浓度
规格
纯化类型
保存液
内含物
保存条件
运输条件
RRID
产品详细信息
Immunogen sequence: HGSPTVTKLS KEPSDTSAAF ESTAKENFLG EDDDFVDLEE LSSQTGGGMH KKDTLKECLS LDPEERKKAE SQINNSAVEM QVQS
Highest antigen sequence identity to the following orthologs: Mouse - 51%, Rat - 55%.
靶标信息
NCOA7 enhances the transcriptional activities of several nuclear receptors. It is involved in the coactivation of different nuclear receptors, such as ESR1, THRB, PPARG and RARA.
仅用于科研。不用于诊断过程。未经明确授权不得转售。
篇参考文献 (0)
生物信息学
蛋白别名: 140 kDa estrogen receptor-associated protein; ERAP140; Estrogen nuclear receptor coactivator 1; estrogen receptor associated protein 140 kDa; interferon-beta inducible alternative start form; Nuclear receptor coactivator 7; putative protein product of Nbla00052; putative protein product of Nbla10993; TBC/LysM-associated domain containing 4; unnamed protein product
基因别名: dJ187J11.3; ERAP140; ESNA1; Nbla00052; Nbla10993; NCOA7; NCOA7-AS; TLDC4
UniProt ID: (Human) Q8NI08
Entrez Gene ID: (Human) 135112